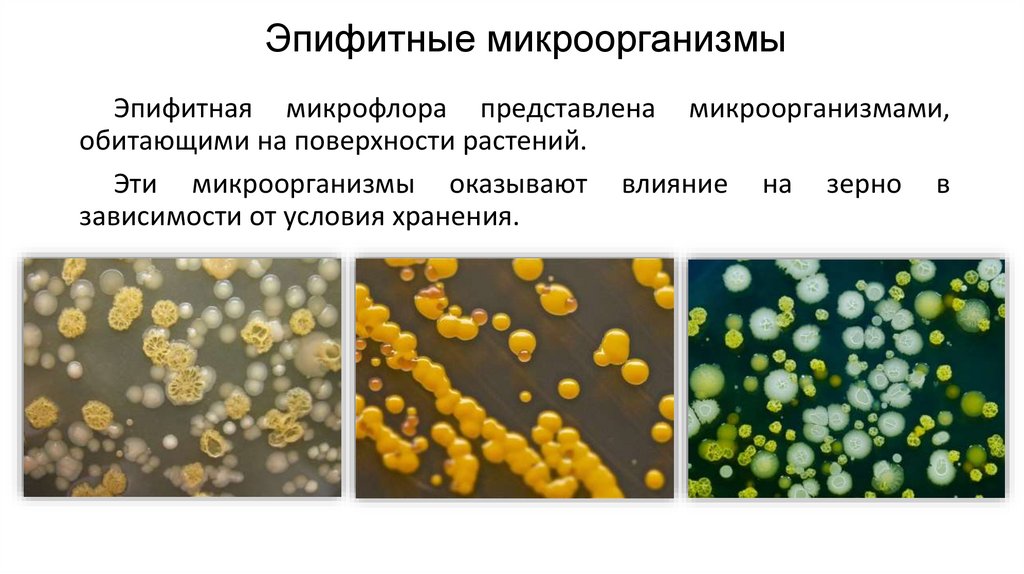
Эпифитные микроорганизмы

Похожие презентации:
Микробиологическая оценка качества зерна
1. Микробиологическая оценка качества зерна
2. Эпифитные микроорганизмы
Эпифитная микрофлора представлена микроорганизмами,обитающими на поверхности растений.
Эти микроорганизмы оказывают влияние на зерно в
зависимости от условия хранения.
3.
Прихранении
зрелого
зерна, в котором вода
находится
в
связанном
состоянии и не доступна
микроорганизмам,
эпифитная
микрофлора
находится
в
состоянии
анабиоза (покоя). Поэтому
правильное хранение зерна
должно сводиться к тому,
чтобы
не
допускать
развитие
на
нем
микроорганизмов
4.
Назерне
повышенной
влажности
микроорганизмы
размножаются тем быстрее, чем выше температура.
Таким образом, развитие микробиологических процессов в
хранящемся зерне с повышенной влажностью приводит к смене
доминирующих форм микроорганизмов, изменению видового
состава эпифитной микрофлоры.
5.
Задание• Навеску зерна массой 5 г помещают в колбу с 50 мл стерильной
водопроводной воды.
• Взбалтывают колбу в течение 10 мин.
• Из полученной вытяжки готовят последовательные разведения
(1:10, 1:100).
• Затем делают посев в чашки Петри со стерильной питательной
средой (по капле из каждого разведения).
• Чашки инкубируют при температуре 30°С.
• Учет проводят через 5-7 дней.
6. Приготовление разведений
7. Посев микрофлоры
8. Учет колоний
Подсчитывают для каждого образца число колониеобразующихединиц (КОЕ) и пересчитывают на 1 г зерна по формуле
А= б • в • г /д
где А – количество КОЕ в 1 г сырого образца;
б – среднее количество колоний на одной чашке;
в – разведение, из которого сделан посев;
г – количество капель в 1 мл;
д – вес анализируемого образца

Биология
Биология








